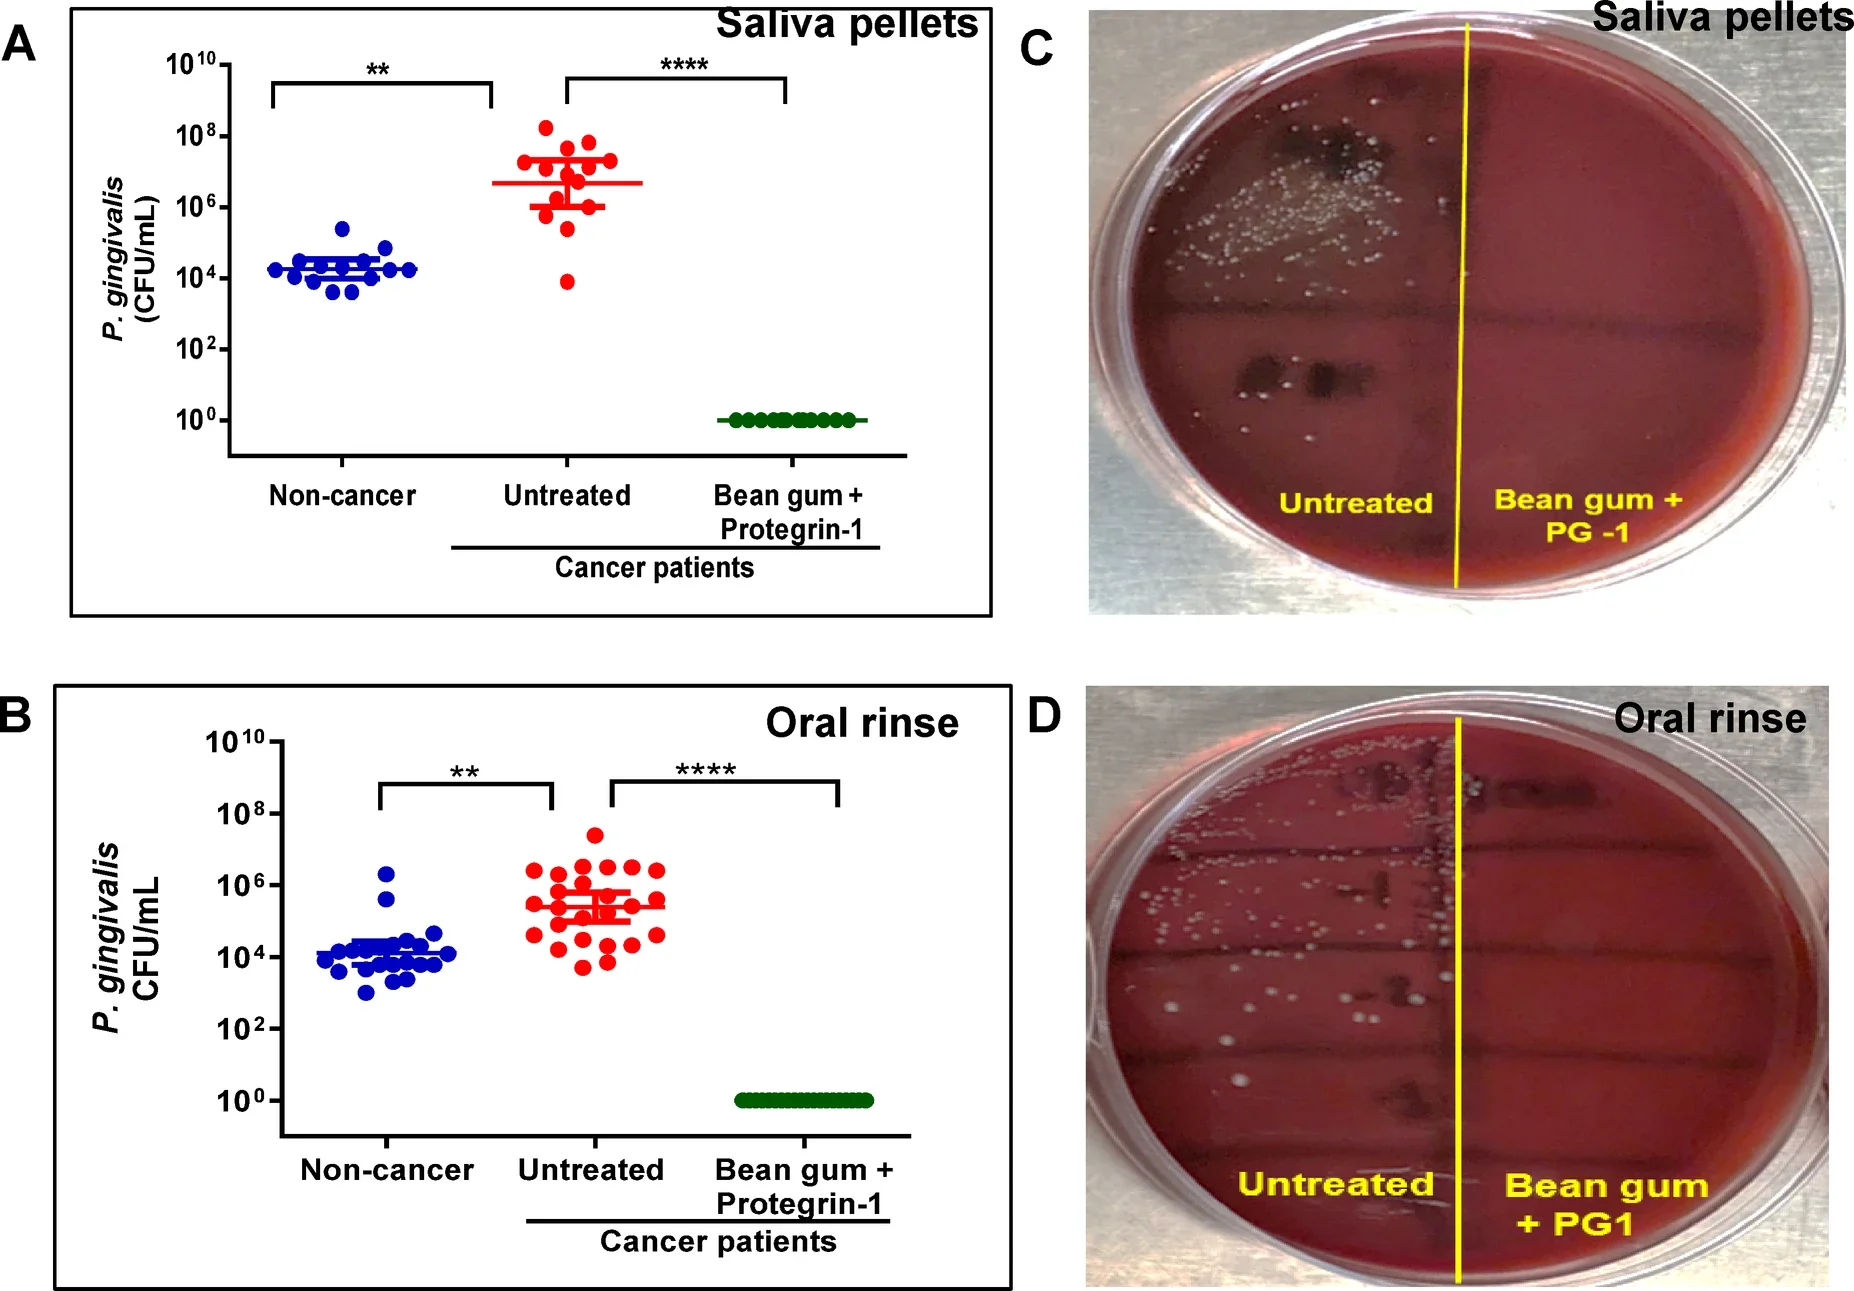
Effect of bean gum+PG1 on Pg in saliva and oral rinse samples of HNSCC patients.
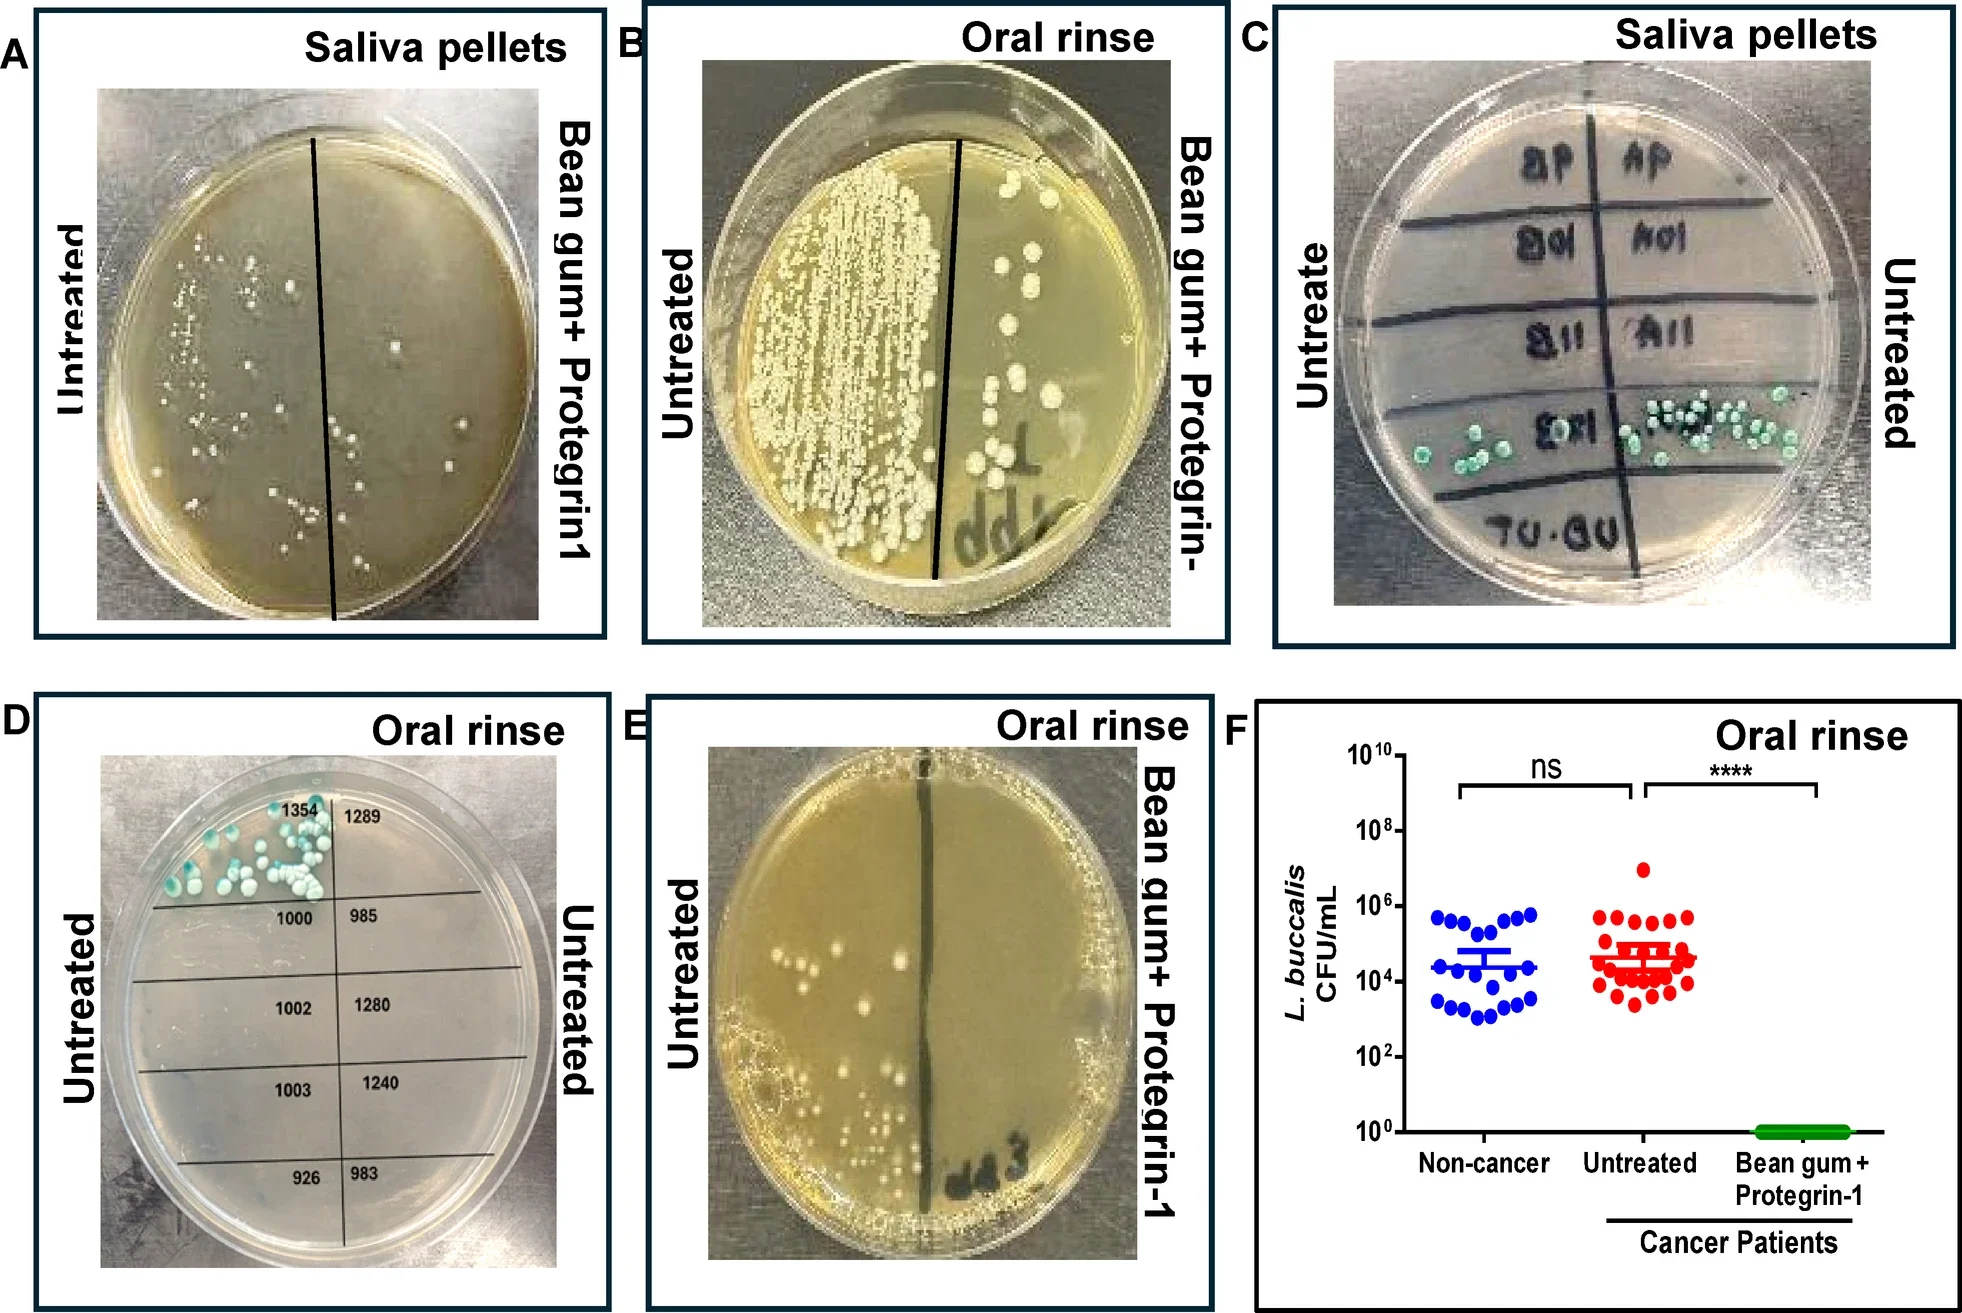
HNSCC associated microbes in saliva (n= 14 non-cancer; n = 16 cancer samples) and oral rinse (n=22 non cancer, n=30 cancer samples) of HNSCC patients and non-cancer cohort.

A piece of chewing gum may sound out of place in a cancer lab. Yet in this case, it became the delivery system for two plant-based compounds. These were aimed at something doctors often struggle to control: the microbes tied to head and neck cancer.
Researchers led by Henry Daniell of the UPenn School of Dental Medicine tested extracts from a bioengineered chewing gum against oral samples from patients with head and neck squamous cell carcinoma, or HNSCC. The gum was built from lablab bean powder and carried two active ingredients, FRIL, a naturally antiviral protein, and protegrin-1, an antimicrobial peptide. Together, they sharply cut levels of three microbes linked to these cancers. These microbes are human papilloma virus, known as HPV, and the bacteria Porphyromonas gingivalis and Fusobacterium nucleatum.
That matters because HNSCC is a common cancer that forms in the lining of the mouth and throat. It can be aggressive, and outcomes are often poor when it is found late. Daniell said many recently approved cancer drugs have not made a major difference in quality of life or five-year survival. As a result, that gap keeps the search open for better add-on treatments.
“The global increase in oropharyngeal cancer is linked to HPV infection,” Daniell said. “And Pg and Fn infections worsen survival rates of untreated recurrent or metastatic oral cancer, even after surgery and risk-adjusted adjuvant, or supplemental, therapies.”

The work builds on earlier efforts using a chewing gum made from lablab beans, also called bean gum. That gum contains FRIL, a lectin with antiviral activity. In this study, the team looked at whether FRIL could trap HPV in saliva and oral rinse samples from cancer patients. Then they added protegrin-1, a peptide known for antimicrobial and anticancer activity. This was to see whether the gum could also suppress the bacteria tied to tumor growth and poor survival.
The researchers used oral samples from patients with HNSCC as well as samples from non-cancer participants. Rather than relying only on DNA or RNA amplification, which cannot tell living microbes from dead ones, they cultured live bacteria and used ELISA to measure viral material. That let them focus on the pathogens still present and potentially active.
HPV turned up in all 14 saliva samples from HNSCC patients tested at one site, and viral levels were far higher than in the non-cancer group. In oral rinse samples from another patient group, about three quarters of the cancer samples were HPV-positive.
After treatment with bean gum extract, HPV levels dropped by about 93% in saliva samples. In oral rinse samples, the reduction was about 80%. In some cases, the gum aggregated all detectable HPV in the sample.
The bacterial results were just as striking, and in some ways more dramatic.

Bean gum by itself had only limited antibacterial power. At best, it lowered Porphyromonas gingivalis and Fusobacterium nucleatum by about one log. At higher concentrations it even appeared to promote growth, possibly because sugars or other bean components fed the bacteria.
That changed when protegrin-1 was added.
In non-cancer clinical samples used to optimize the dose, the combination of bean gum and protegrin-1 cut the bacterial counts by 2 to 3 logs at one dose level. At the higher protegrin dose, both bacteria were completely eliminated in those test samples. That dose was then used in the cancer-patient samples.
In saliva and oral rinse from patients with HNSCC, the combination reduced P. gingivalis by 4 to 6 logs, or about 99.97% to 100%. It produced a similar 4 to 6 log reduction for F. nucleatum. The treatment worked after a single one-hour exposure.
Those two microbes are not minor passengers. Both have been linked to cancer-promoting inflammation, invasion, metastasis and immune evasion. The study noted that high abundance of oral HPV, P. gingivalis and F. nucleatum correlates with worse survival in patients with HNSCC.
The cancer samples also carried much heavier bacterial loads than the non-cancer controls. In some cases, counts were 100 to 1,000 times higher.
One of the more notable parts of the study was what the treatment did not do.
The gum-plus-protegrin mix had minimal effect on many of the mouth’s nonpathogenic bacteria. Streptococci species, for example, were only partly reduced or not substantially reduced. Likely some are protected by capsules or biofilms. That selective effect stands in contrast to radiation therapy, which the researchers said can reduce beneficial oral bacteria while increasing disease-causing yeast such as Candida albicans.
The team also found low levels of Candida albicans in a small fraction of cancer samples, but none in the non-cancer group. Another organism, Leptotrichia buccalis, appeared often in cancer patients’ oral rinse samples and was cut by more than 99% with treatment.
This narrower microbial hit could matter. A treatment that lowers the pathogens most closely tied to tumor progression, while leaving more of the normal oral microbiome intact, may offer an advantage over approaches that disrupt the mouth more broadly.
The gum also has practical appeal. The lablab bean powder it uses has already received Generally Recognized as Safe status. The amount in each gum tablet is far below the quantity consumed in food-based toxicology testing. Daniell’s group also reported that FRIL in the gum remains stable for long periods at room temperature.
The study did not test the gum in patients as a treatment trial. This was an ex vivo study, meaning the team worked on saliva and oral rinse samples collected from patients, not inside the human body over time.
That is an important limit. The researchers did not monitor long-term changes in the oral microbiome, and they did not yet test how well FRIL and protegrin penetrate tumor cells in patients. They also noted that periodontal disease was not examined or recorded, so they could not rule out whether some of the rise in P. gingivalis was tied to gum disease rather than cancer alone.
Still, the findings point toward an intriguing strategy. Instead of focusing only on the cancer cells themselves, the gum targets viruses and bacteria that may help start the disease, drive recurrence or worsen survival.
“Lip and oral cavity cancer was the seventh leading cancer type in cancer incidence and mortality rate worldwide in adolescents, young adults, and middle-aged adults in 2022,” Daniell said. “Our findings support the value of advancing these therapies to clinical trials as adjuvants with current treatments or as prophylaxis to prevent infection and transmission.”
This work suggests that a low-cost chewing gum could someday serve as an add-on to standard care for head and neck cancer, or possibly as a preventive step for people at risk of transmitting or carrying these microbes. Its biggest promise is local action in the mouth. This is where HPV, P. gingivalis and F. nucleatum may contribute to cancer development and recurrence.
For now, the findings are an early step, not a clinical answer. But the approach stands out because it combines affordability, targeted antimicrobial action and an easy delivery method.
If later clinical trials confirm the effect in patients, the gum could offer a simpler way to reduce dangerous oral microbes without wiping out the whole microbial community.
Research findings are available online in the journal Scientific Reports.
The original story “UPenn researchers develop bioengineered chewing gum to fight head and neck cancers” is published in The Brighter Side of News.
Like these kind of feel good stories? Get The Brighter Side of News’ newsletter.
The post UPenn researchers develop bioengineered chewing gum to fight head and neck cancers appeared first on The Brighter Side of News.